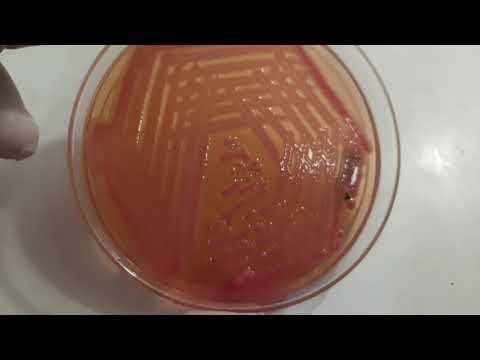
Acinetobacter, Klebsiella and Bacillus growth on culture media and Gram Stain Microscopy смотреть онлайн

Автор / Канал: Лекторская атмосфера Страница 16

Эволюция #2

Review Acnes Pore Strip Mengangkat Komedo

Отдаваясь воле

Фитиль "По всей форме" 1965 года

Luke 18:28-43 A blind man’s keen insight (5-28-2023)

Girl face #gouache #layercake paint #ink

Микробы

Я СДЕЛАЛ ЕЩЁ 15 ПЕСЕН ДЛЯ ЭТОГО ВИДЕО

Играем в приват сервер майнкрафт 1 16 5 в мой День Рождения

FMDors 2

Plasma Clean Air Monitors (1 minute)

Game Master @BOTANICA

Выпуск 30. История заставок шоу перевоплощений «Один в один!».

Jai wolf feat marshmallow || indian summer || AMF 2018

Bandquest 2019 First Impressions - The Story (Brandi Carlile Cover)

👉What is Neuron? 🔥|Full explanation of Neuron with Simple Definition| 🔥Importance of Neuron?

Survivre dans un monde post apo contrôlé par les robots - Generation Zero #1

Чудеса Аллаха

Марина Долженко
Acinetobacter, Klebsiella and Bacillus growth on culture media and Gram Stain Microscopy

FD Day 2021 - Clinical Session

Клип я сигма-1:31

Ген. репетиция

Indila Mini World
За каждым успешным каналом стоит личность, идея и сотни часов кропотливого труда. Если вы здесь, значит, автор «Лекторская атмосфера» уже сумел зацепить ваше внимание своим уникальным стилем или подачей. А мы на RUVIDEO позаботились о том, чтобы вы могли изучить весь архив его работ в максимально комфортных условиях — без лишней суеты и преград.
Почему за работами канала «Лекторская атмосфера» так интересно наблюдать? Всё просто: это честный контент, который находит отклик в сердцах зрителей. На нашем ресурсе вы можете смотреть онлайн все видео любимого автора бесплатно и в хорошем качестве. Нам важно, чтобы вы видели каждую деталь и слышали каждый нюанс, поэтому мы используем только стабильные плееры из открытых источников Rutube.
Следите за новинками канала, пересматривайте старые шедевры и открывайте для себя новые грани творчества «Лекторская атмосфера». Мы постоянно обновляем ленту, чтобы у вас под рукой всегда были самые свежие выпуски. Никаких сложных регистраций — только вы и творчество, которое вдохновляет. Приятного вам путешествия по миру авторского контента на RUVIDEO!
Видео взято из открытых источников Rutube. Если вы правообладатель, обратитесь к первоисточнику.